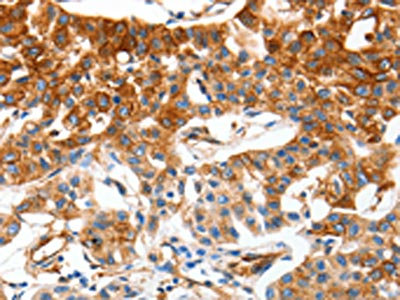

MCAM Antibody
-
中文名稱:MCAM兔多克隆抗體
-
貨號(hào):CSB-PA066991
-
規(guī)格:¥1100
-
圖片:
-
The image on the left is immunohistochemistry of paraffin-embedded Human lung cancer tissue using CSB-PA066991(MCAM Antibody) at dilution 1/50, on the right is treated with synthetic peptide. (Original magnification: ×200)
-
The image on the left is immunohistochemistry of paraffin-embedded Human renal cancer tissue using CSB-PA066991(MCAM Antibody) at dilution 1/50, on the right is treated with synthetic peptide. (Original magnification: ×200)
-
Gel: 8%SDS-PAGE, Lysate: 40 μg, Lane: Human leiomyosarcoma tissue, Primary antibody: CSB-PA066991(MCAM Antibody) at dilution 1/850, Secondary antibody: Goat anti rabbit IgG at 1/8000 dilution, Exposure time: 10 seconds
-
-
其他:
產(chǎn)品詳情
-
Uniprot No.:
-
基因名:
-
別名:A32 antigen antibody; CD 146 antibody; CD146 antibody; CD146 antigen antibody; Cell surface glycoprotein MUC18 antibody; Cell surface glycoprotein P1H12 antibody; Gicerin antibody; Mcam antibody; Melanoma adhesion molecule antibody; Melanoma associated antigen A32 antibody; Melanoma associated antigen MUC18 antibody; Melanoma associated glycoprotein MUC18 antibody; Melanoma cell adhesion molecule antibody; Melanoma-associated antigen A32 antibody; Melanoma-associated antigen MUC18 antibody; MelCAM antibody; MUC 18 antibody; MUC18 antibody; MUC18_HUMAN antibody; S endo 1 antibody; S endo 1 endothelial associated antigen antibody; S-endo 1 endothelial-associated antigen antibody
-
宿主:Rabbit
-
反應(yīng)種屬:Human
-
免疫原:Synthetic peptide of Human MCAM
-
免疫原種屬:Homo sapiens (Human)
-
標(biāo)記方式:Non-conjugated
-
抗體亞型:IgG
-
純化方式:Antigen affinity purification
-
濃度:It differs from different batches. Please contact us to confirm it.
-
保存緩沖液:-20°C, pH7.4 PBS, 0.05% NaN3, 40% Glycerol
-
產(chǎn)品提供形式:Liquid
-
應(yīng)用范圍:ELISA,WB,IHC
-
推薦稀釋比:
Application Recommended Dilution ELISA 1:2000-1:5000 WB 1:500-1:2000 IHC 1:50-1:200 -
Protocols:
-
儲(chǔ)存條件:Upon receipt, store at -20°C or -80°C. Avoid repeated freeze.
-
貨期:Basically, we can dispatch the products out in 1-3 working days after receiving your orders. Delivery time maybe differs from different purchasing way or location, please kindly consult your local distributors for specific delivery time.
-
用途:For Research Use Only. Not for use in diagnostic or therapeutic procedures.
相關(guān)產(chǎn)品
靶點(diǎn)詳情
-
功能:Plays a role in cell adhesion, and in cohesion of the endothelial monolayer at intercellular junctions in vascular tissue. Its expression may allow melanoma cells to interact with cellular elements of the vascular system, thereby enhancing hematogeneous tumor spread. Could be an adhesion molecule active in neural crest cells during embryonic development. Acts as surface receptor that triggers tyrosine phosphorylation of FYN and PTK2/FAK1, and a transient increase in the intracellular calcium concentration.
-
基因功能參考文獻(xiàn):
- MCAM coordination of apical-basal polarity and planar cell polarity provides insight into the general mechanisms of morphogenesis. PMID: 28589943
- CD146 suppresses BC progression as a target of CD44-downstream signaling PMID: 29121955
- Cultured early passage ASCs contained low levels of CD146 mRNA, which was expressed in two different splicing variants, at a relatively high amount of the CD146-long form and at a relatively low amount of the CD146-short form. ASCs contained low levels of CD146 protein, which consisted predominantly long form and a small amount of short form. PMID: 28549249
- In summary, we have shown that MUC18/Muc18 may serve as a regulator of airway inflammation and mucus overproduction, two important features of type 2-high asthma. Our data suggest that MUC18/Muc18 or its downstream signaling mediators may be targets for potential therapeutic agents. PMID: 28451734
- CD146 promoter polymorphisms were not associated with the risk of clear cell renal carcinoma in Chinese population. The rs3923594 was an independent predictor of recurrence in with localized ccRCC. PMID: 28626293
- We demonstrate that ER(+) breast cancers contain two CAF subtypes defined by CD146 expression. CD146(neg) CAFs suppress ER expression in ER(+) breast cancer cells, decrease tumor cell sensitivity to estrogen, and increase tumor cell resistance to tamoxifen therapy PMID: 27702820
- CD146 functions as a suppressor of tumorigenesis and cancer stemness in CRC through inactivating the canonical Wnt/beta-catenin cascade PMID: 27302922
- data identify the anatomy and phenotype of a novel class of committed myogenic progenitor in human post-natal skeletal muscle of subendothelial cells associated with the abluminal surface of microvascular compartment distinct from satellite cells PMID: 29186180
- These findings identify CD146 as a novel retention signal that traps macrophages within the artery wall, and a promising therapeutic target in atherosclerosis treatment. PMID: 28084332
- CD146 was expressed in all cases of Ph-positive B- cell acute lymphoblastic leukemia and in the vast majority of T-cell acute lymphoblastic leukemia PMID: 26102234
- Our results suggest that MCAM may serve as a novel therapeutic target to overcome chemoresistance in SCLC. PMID: 28646020
- Authors show that KDM3A regulates MCAM expression both through a direct mechanism, involving modulation of H3K9 methylation at the MCAM promoter, and an indirect mechanism, via the Ets1 transcription factor. PMID: 28319067
- increment of CD146 expression indicates gradual change of cultured annulus fibrosus cells to express a contractile phenotype and that transforming growth factor beta1 enhances this cellular commitment PMID: 27273299
- CD146 positivity in immunohistological analysis of 11 MRT patient samples was associated with poor patient outcomes. These results suggest that CD146 defines a distinct sub-population in MRT with high tumorigenic capacity and that this marker represents a promising therapeutic target. PMID: 27041577
- Promoter methylation of MCAM, ERalpha and ERbeta have a potential to be utilized as biomarker for the early detection of prostate cancer (PC) as their sensitivity and specificity seem to be better than serum PSA. PMID: 28147335
- MCAM promotes tamoxifen resistance by transcriptionally suppressing ERalpha expression and activating the AKT pathway, followed by induction of epithelial-mesenchymal transition. PMID: 27838413
- High MCAM expression is associated with lung metastasis in malignant melanoma. PMID: 27151304
- Results provide evidence that MUC18 promotes viral infections both in vivo and in vitro. PMID: 27701461
- soluble CD146 is released from the peripheral vasculature in response to venous stretch and may reflect systemic congestion in chronic heart failure patients PMID: 28062630
- results indicate that CD146 can be targeted in vivo by the radiolabeled OI-3 antibodies PMID: 27776176
- Findings suggest that decreased CD146 expression in cancer-associated fibroblasts promotes pancreatic cancer progression. PMID: 26373617
- METCAM/MUC18 positively promotes tumorigenesis of human breast cancer SK-BR-3 cells via increasing the signal in survival and proliferation pathways. PMID: 27125403
- sCD146 levels are elevated in patients with systemic sclerosis, but decreased sCD146 levels are observed in SSc patients with pulmonary arterial hypertension PMID: 27726047
- Nestin and CD146 are expressed in breast cancer cells with highly aggressive potency. They might contribute to disease relapse in breast cancer by activating the epithelial-mesenchymal transition pathway and assist tumor neovascularization. PMID: 28347241
- The results demonstrated isolation of specific scFv with frequency of 40 % which showed significant binding with the epitope in both ELISA and fluorescence-activated cell sorting (FACS) analyses. The antibody inhibited the migration (76 %) and invasion (67 %) of MUC18 positive cell line. The results suggest the specific anti-MUC18 scFv as an effective antibody for breast cancer immunotherapy PMID: 27565656
- We provide the first report that pro-angiogenic genes PECAM1, PTGS1, FGD5, and MCAM may play a vital role in pathological dermal angiogenesis disorders of psoriasis. PMID: 26748901
- Results showed that increased human METCAM/MUC18 expression in ovarian cancer SK-OV-3 cells suppressed tumorigenesis and ascites formation in nude mice, suggesting that human METCAM/MUC18 plays a suppressor role in the progression of ovarian cancer, perhaps by reducing proliferation and angiogenesis. PMID: 26906545
- CD146 dexpression efines a subpopulation of human mesenchymal stem cells capable of bone formation and in vivo trans-endothelial migration. PMID: 26753846
- Results showed that CD146 promoted metastasis of hepatocellular carcinoma (HCC) cells and predicted poor prognosis of HCC patients. CD146 induced epithelial mesenchymal transition through probably IL-8 up-regulation and STAT1 down-regulation. PMID: 26928402
- Data indicate that CD146 antigen is an effective cell surface marker for enriching tumor-propagating cells (TPCs) in primary sarcomas. PMID: 26517673
- MUC18 is an independent prognostic factor for clear cell renal cell carcinoma PMID: 26617818
- CD146 is a novel and useful marker for predicting senescence in human umbilical cord blood-derived Mesenchymal stem cells (hUCB-MSCs), and CD146 can potentially be applied in quality-control assessments of hUCB-MSC-based therapy. PMID: 26941359
- ZBTB7A directly binds to the promoter and transcriptionally represses the expression of MCAM, establishing ZBTB7A as a bona fide transcriptional repressor of MCAM PMID: 25995384
- The expression of CD146 and HIF1a was positively correlated with EGFR and CD31, respectively in salivary gland adenoid cystic carcinoma. PMID: 25997612
- a model that CD166 regulates MCAM through a signaling flow from activation of PI3K/AKT and c-Raf/MEK/ERK signaling to the inhibition of potential MCAM ubiquitin E3 ligases, betaTrCP and Smurf1 PMID: 26004137
- Combined EpCAM/MCAM CellSearch enrichment thus increased the CTC detection rate. PMID: 25552367
- Results identified MCAM as a novel YAP target in hepatocellular carcinoma (HCC) but not in breast and colon cancer cells. MCAM serum levels were specifically elevated in HCC suggesting it as a specific diagnostic tool for HCC. PMID: 25728681
- CD146, P53, and Ki-67 are overexpressed in uterine sarcoma PMID: 26293576
- These data suggest CDCP1 expression can be used to identify a subset of marrow fibroblasts functionally distinct from CD146+ fibroblasts. PMID: 25275584
- Results show that that CD146 is expressed in 41% of gastric neoplasm cells and correlated positively with lymph node metastasis and epithelial-mesenchymal transition markers making it a good prognostic factor. PMID: 22754372
- MCAM is a major GAL-1 ligand is largely dependent on melanoma malignancy. PMID: 25756799
- MCAM is expressed by effector CD8+ T lymphocytes and it is strikingly upregulated during multiple sclerosis relapses. MCAM blockade restricts the transmigration of CD8(+) T lymphocytes across human blood-brain barrier endothelial cells. PMID: 25869475
- HuMETCAM/MUC18 levels in ovarian carcinomas and metastatic lesions were significantly higher than in normal tissues and cystadenomas. PMID: 25510693
- In peripheral stenotic arteriosclerotic disease the proangiogenic potency of MUC18 may play a role in angiogenesis of collaterals, whereas in dilatative aortic diseases the induction of collaterals is typically not evident. PMID: 25729916
- Suggest endothelial CD146 as a target for specific drug delivery in hepatocellular carcinoma. PMID: 25238265
- Data proposed a novel signaling mechanism by which Sema 3A regulates PTEN, FOXO 3a and MelCAM in a coordinated manner that leads to suppression of breast cancer growth and angiogenesis. PMID: 24727891
- Authors conclude therefore that ETs upregulate MCAM in an Akt and ERK/MEK-dependent, but CREB-independent manner, providing an understanding for possible pharmacologic intervention in progressing melanoma. PMID: 24743054
- expression behaves as a molecular warning of melanoma progression PMID: 24902661
- With the ability of migration and survival in the advanced osteoarthritis cartilage, CD146+ chondroprogenitors might be "tissue-specific" for cartilage tissue regeneration. PMID: 25266708
- functional characterization of N-acetylglucosaminyltransferases III and V in human melanoma cells PMID: 24726881
顯示更多
收起更多
-
亞細(xì)胞定位:Membrane; Single-pass type I membrane protein.
-
組織特異性:Detected in endothelial cells in vascular tissue throughout the body. May appear at the surface of neural crest cells during their embryonic migration. Appears to be limited to vascular smooth muscle in normal adult tissues. Associated with tumor progress
-
數(shù)據(jù)庫鏈接:
Most popular with customers
-
-
YWHAB Recombinant Monoclonal Antibody
Applications: ELISA, WB, IHC, IF, FC
Species Reactivity: Human, Mouse, Rat
-
Phospho-YAP1 (S127) Recombinant Monoclonal Antibody
Applications: ELISA, WB, IHC
Species Reactivity: Human
-
-
-
-
-